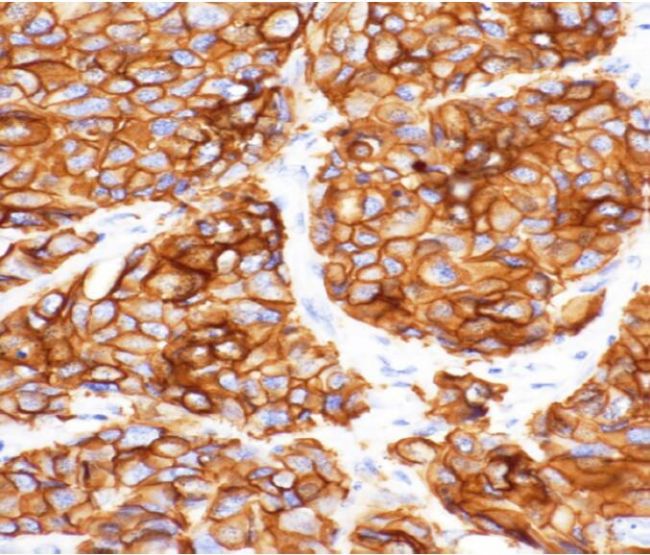
圖片

新年在即,Evident的DP顯微數(shù)碼相機(jī)家族又迎來一全新“成員”——DP75!DP75開創(chuàng)了顯微成像的新紀(jì)元。一機(jī)在手,讓您輕松應(yīng)對(duì)各種常規(guī)顯微成像應(yīng)用,助力研究人員和檢測(cè)人員捕獲從明場(chǎng)到熒光,甚至是近紅外(NIR)范圍內(nèi)的高分辨率圖像。這款創(chuàng)新型相機(jī)簡(jiǎn)化了顯微成像過程,可使您更加專注于自己的實(shí)驗(yàn)。
01
超高分辨率,細(xì)節(jié)更清晰

02
12軸校正,讓色彩還原更精準(zhǔn)

12區(qū)示意圖

樣品:HE染色結(jié)腸
03
Peltier制冷,信噪比更佳


04
寬光譜,拓展紅外成像邊界

樣品:Ptk2,染色:Cy7

IR截至濾鏡切換桿
05
AI識(shí)別場(chǎng)景,采集更便利

AI自動(dòng)識(shí)別對(duì)比圖
06
手動(dòng)拼接明場(chǎng)和熒光大圖

手動(dòng)熒光拼圖
07
線性模式采集,實(shí)現(xiàn)定量分析

Evident提供了滿足不同應(yīng)用需求的多款顯微數(shù)碼相機(jī)。在選擇您需要的相機(jī)時(shí),合適的參數(shù)至關(guān)重要;我們不同型號(hào)的顯微相機(jī)可涵蓋從一般生物學(xué)研究、教學(xué)、病理研究、細(xì)胞培養(yǎng)、胚胎學(xué)和藥物研發(fā)等的多種應(yīng)用場(chǎng)景。Evident的DP顯微數(shù)碼相機(jī)家族產(chǎn)品適用于包括熒光、明場(chǎng)和紅外成像在內(nèi)的多種觀察方法。

Evident了解成像對(duì)于您的重要性,我們的顯微數(shù)碼相機(jī)以先進(jìn)的光學(xué)器件、出色的細(xì)節(jié)和智能成像功能幫助您觀察圖像細(xì)節(jié)并提高工作質(zhì)量。
更多有關(guān)DP75顯微數(shù)碼相機(jī)信息,歡迎點(diǎn)擊此處獲取。